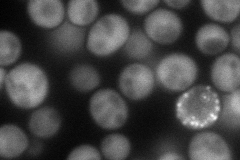
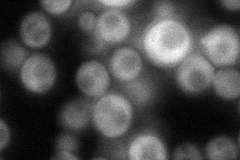
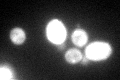

View description
Protein required for efficient mating; involved in shmoo formation and nuclear migration in the pre-zygote; associates with ribosomes and interacts with Get4p; has a possible role in insertion of tail-anchored proteins into the ER membrane
Localization:
Intensity:
Fold change:
Significance:
-
C’ GFP library in SD

cytosol91.01 -
N' NOP1pr-GFP in SD
cytosol97.4475 -
N' TEF2pr-mCherry in SD

cytosol,nucleus0 -
N' NATIVEpr-GFP in SD
cytosol,punctate89.4543 -
N' TEF2pr-VC and Cyto-VN in SD

cytosol37.7993 -
C’ GFP library in SD+DTT
cytosol97.451.07No -
C’ GFP library in SD+H2O2

punctateN/AN/ANo -
C’ GFP library in Starvation Media

punctateN/AN/AYes -
C’ GFP library on the background of Pup2-DaMP

cytosol -
C’ GFP library on the background of CCT mutant

cytosol95.20181.04597No
